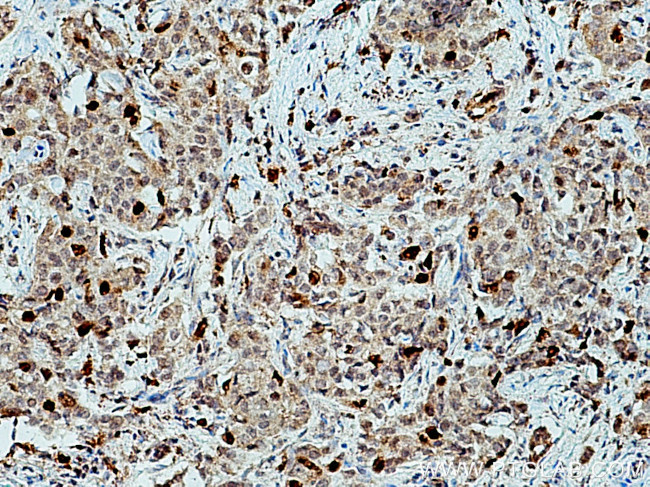
KIF20A Antibody in Immunohistochemistry (Paraffin) (IHC (P))

Search
Proteintech
KIF20A Polyclonal Antibody
{{$productOrderCtrl.translations['antibody.pdp.commerceCard.promotion.promotions']}}
{{$productOrderCtrl.translations['antibody.pdp.commerceCard.promotion.viewpromo']}}
{{$productOrderCtrl.translations['antibody.pdp.commerceCard.promotion.promocode']}}: {{promo.promoCode}} {{promo.promoTitle}} {{promo.promoDescription}}. {{$productOrderCtrl.translations['antibody.pdp.commerceCard.promotion.learnmore']}}
产品信息
15911-1-AP
种属反应
已发表种属
宿主/亚型
分类
类型
抗原
偶联物
形式
浓度
规格
纯化类型
保存液
内含物
保存条件
运输条件
产品详细信息
Immunogen sequence: MSQGILSPP AGLLSDDDVV VSPMFESTAA DLGSVVRKNL LSDCSVVSTS LEDKQQVPSE DSMEKVKVYL RVRPLLPSEL ERQEDQGCVR IENVETLVLQ APKDSFALKS NERGIGQATH RFTFSQIFGP EVGQASFFNL TVKEMVKDVL KGQNWLIYTY GVTNSGKTHT IQGTIKDGGI LPRSLALIFN SLQGQLHPTP DLKPLLSNEV IWLDSKQIRQ EEMKKLSLLN GGLQEEELST SLKRSVYIES RIGTSTSFDS GIAGLSSISQ CTSSSQLDET SHRWAQPDTA PLPVPANIRF SIWISFFEIY NELLYDLLEP PSQQRKRQTL RLCEDQNGNP YVKDLNWIHV QD (1-351 aa encoded by BC012999)
靶标信息
Mitotic kinesin required for chromosome passenger complex (CPC)-mediated cytokinesis. Following phosphorylation by PLK1, involved in recruitment of PLK1 to the central spindle. Interacts with guanosine triphosphate (GTP)-bound forms of RAB6A and RAB6B. May act as a motor required for the retrograde RAB6 regulated transport of Golgi membranes and associated vesicles along microtubules. Has a microtubule plus end-directed motility. [UniProt]
仅用于科研。不用于诊断过程。未经明确授权不得转售。
生物信息学
蛋白别名: GG10_2; kinesin-like protein; Kinesin-like protein KIF20A; Mitotic kinesin-like protein 2; MKlp2; RAB6 interacting, kinesin-like (rabkinesin6); Rab6-interacting kinesin-like protein; Rabkinesin-6; unnamed protein product
基因别名: KIF20A; MKLP2; RAB6KIFL; RCM6
UniProt ID: (Human) O95235
Entrez Gene ID: (Human) 10112